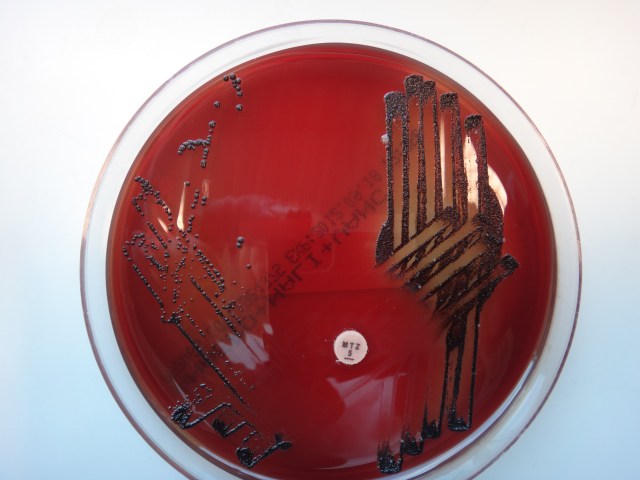

These so-called first generation cephalosporins (C1) remain important agents for skin, soft tissue and urinary tract infections due to susceptible organisms and for surgical prophylaxis. Increases in community acquired MRSA in some regions may lead to a different empiric choice for skin/soft tissue infection (e.g. doxycycline or trimethoprim+sulphamethoxazole). Local cumulative antibiograms should also be examined to […]

Blood cultures give a critically important window on bacterial and fungal sepsis, providing direct patient treatment guidance and reliable antimicrobial susceptibility data that are used to construct cumulative antibiograms and empirical treatment guidelines. They also help to rule out serious bacterial infection, provided that collection occurs prior to antibiotic treatment and an adequate patient sample is taken. Here […]
The normal adult human body is composed of approximately 10^13 cells.
For many years, antibiotic prophylaxis was routinely administered before dental and other procedures to patients with cardiac conditions that carry a high lifetime risk of infective endocarditis. However due to the infrequent occurrence of endocarditis, prophylaxis prevents very few cases. Infective endocarditis is more likely to result from bacteraemia associated with daily activities (e.g. tooth […]
Tailed phages are a kind of bacteriophage— viruses that infect bacteria. They are the most abundant organism on Earth, with an estimated 10^31 particles in our biosphere.
Antibiograms summarise local antimicrobial susceptibility in order to guide appropriate antimicrobial prescribing. Ideally they are updated annually by microbiology services to provide a current picture of bacterial susceptibility and the local incidence of key sentinel resistant pathogens.

Confine testing to symptomatic patients. Testing of patients with formed stools may generate false positives due to asymptomatic carriage of toxigenic strains. An unfortunate side effect of multiplex PCR stool assays, are that tests that are inappropriate to the clinical circumstance may be performed, generating false positives. Also test at-risk (i.e. antibiotic or ppi-exposed) symptomatic […]

This excellent recent paper from Sarma et al brings focus on what the target level of quinolone use should be in order to have an impact on quinolone resistance in Enterobacteriaceae. It describes the situation across a region of England (9 hospitals and other facilities) where quite stringent control of cephalosporin use was already in place […]

